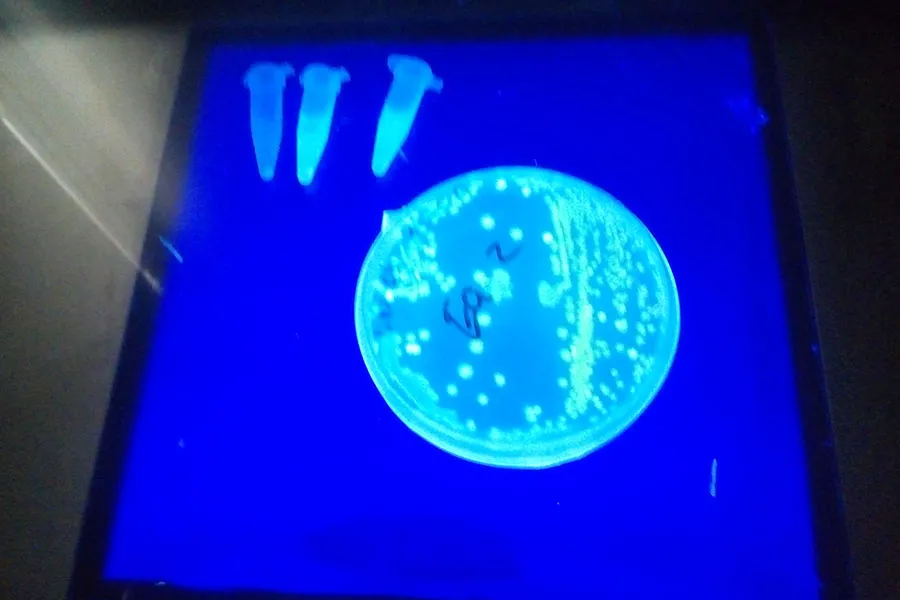

David Ramírez llegó al Tec con un objetivo: apoyar a otros jóvenes como lo apoyaron a él.
Para cumplir con ese deber, el graduando de la generación junio 2020 en Ingeniería en Innovación y Desarrollo aplicó sus conocimientos a proyectos sociales de alto impacto en comunidades del país.
Dentro de su trascendencia en el Tec de Monterrey se encuentra el proyecto de pintura fotoluminiscente que dio luz y vida a diferentes espacios en zonas marginadas.
Desde los 13 años el originario de Baja California ha impulsado el liderazgo juvenil, sin embargo señaló que no fue hasta llegar al Tec cuando descubrió que pudo dar vida a sus planes.
“Con las herramientas que da el Tec se pueden volver realidad las ideas, yo me di cuenta de que podía volver realidad las mías e impactar, es ese click que me dieron”, comentó.
“Me di cuenta de que yo podía hacer un cambio, que en realidad era posible que yo como persona podía generar un impacto”, dijo.

Por su labor social el estudiante de 22 años, que forma parte de la segunda generación del programa Líderes del Mañana, ha contribuido a estados como Chiapas y Nuevo León.
Líderes del Mañana es una iniciativa del Tecnológico de Monterrey que beca al 100 por ciento a jóvenes talentosos de recursos económicos limitados para estudiar carreras en la institución.
Su gran apoyo y trascendencia a causas sociales lo hicieron acreedor al Premio Nacional de la Juventud 2015 en la categoría “Compromiso Social” otorgado por el Gobierno Federal de la República Mexicana.
COMPROMISO CON LA SOCIEDAD
La pasión de David por ayudar a otros no tuvo límites, pues participó en diversos proyectos con los que rebasó las horas de servicio social que se piden como estudiante.
Con el propósito de impulsar a las personas a desarrollar su sentido emprendedor, el alumno apoyó en el Laboratorio de Emprendimiento Social durante su segundo semestre carrera.
“Fueron mis primeros acercamientos al servicio social del Tec y vi que hay más personas comprometidas, que hay más compañeros que les gusta hacer eso y que quieren apoyar a los demás”, dijo.
Su compromiso social viajó durante tres veranos a Chiapas, ya que como parte de Semestre i decidió apoyar a comunidades cafetaleras a desarrollar un proyecto de turismo sustentable.
“Fue una experiencia transformadora, tanto vivir en otro contexto como ayudar a los demás, es lo que me apasiona, fue muy padre combinar mis estudios y darles este propósito”, dijo entusiasmado.

Como parte de su servicio social, el estudiante también se sumó a Líderes con Sentido Humano para acompañar a alumnos en sus vivencias de servicios sociales, además de ser guía de coordinadores.
“Fue muy buen trabajo, me gustó mucho poder hacer interacción e impactar a través de los demás y cómo hacer que los demás entiendan y sientan eso que yo vivo al querer ayudar a los demás”, señaló.
“Mi experiencia fue transmitir esa energía y ese sentimiento a los demás para que puedan replicar este proceso”.
La labor social de David Ramírez se hizo notar hasta en la oscuridad.
El alumno, junto a otros compañeros, desarrolló en 2018 una empresa de pinturas fotoluminiscente que brillaban con el fin de iluminar espacios donde no hay luminarias.
Esta acción social, que nació en clases, llegó al Cerro de la Campana, en Monterrey, y se usó en actividades artísticas y de desarrollo motriz en niños de escuelas de Santa Catarina.
“Ganamos varios premios, desde un Business Model Challenge hasta el Premio Santander a la Innovación Empresarial, ganamos un millón de pesos en el Xignux Challenge”, dijo.
Con el premio, David y los compañeros continuaron realizando acciones sociales a través de la tecnología y en proyectos de urbanismo en apoyo a comunidades y escuelas.
“Extendí mi visión con todo lo realizado, me ayudó a darle sentido a muchas cosas, tanto mi propósito de vida, lo que quisiera hacer y cómo quisiera impactar en el mundo”, destacó.

CON GRAN VISIÓN
El Líder del Mañana dijo que obtuvo cuatro valiosas herramientas del Tecnológico de Monterrey: visión, enseñanzas académicas, extracurriculares y experiencias de labor social.
Durante sus 10 semestres de estancia en el campus Monterrey, David reconoció que enfrentó diversos obstáculos durante su carrera, entre ellos la dura pérdida de su padre.
El estudiante dedicó su título universitario a su papá y en general a toda su familia, a quienes les compartió un emotivo mensaje.
“Muchas gracias por todo, han sido épocas y situaciones difíciles, pero siempre estuvieron ahí para mí, dedicarles el título de mis estudios es lo menos que puedo hacer para agradecerles”, dijo.
Ante la situación que se vive por la pandemia, David pidió a sus compañeros innovar con grandes ideas que apoyen a la sociedad.
“A mis profesores muchas gracias, me dieron las herramientas en cuanto a conocimientos y para ser quien soy ahora, me ayudaron a reflexionar y abrir mi panorama con las materias”, agregó.

El EXATEC, que actualmente trabaja como científico de datos, dijo que se irá del Tec con el sueño de transformar la vida de personas en México con negocios o empresas de impacto social.
“Los negocios pueden transformar la vida de los demás, y cambiar este paradigma de una empresa capitalista a una empresa que genere valor a las personas, en lo económico y en el ambiente”, señaló.
“El compromiso que me llevo es el poder hacer el cambio que el Tec me enseñó que puedo hacer y en cuanto a Líderes del Mañana este compromiso de apoyar a otros es recíproco”.
Con información de Paulina Sánchez
SEGURAMENTE QUERRÁS LEER TAMBIÉN: